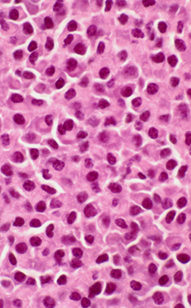

Author: Wakenda K. Tyler, MD and Vikranth Mirle, MD
Description
Multiple myeloma is a cancer of plasma cells, a type of white blood cell that normally produce antibodies to fight infections. In multiple myeloma, these cells grow out of control resulting in damage to the organs including the bones and kidneys. Multiple myeloma is the most common type of cancer that starts in the bone itself (a primary bone cancer).
Symptoms
Common symptoms of multiple myeloma include bone pain (often in the back, hips, ribs, or skull) and fractures that happen with little or no injury, called “pathologic fractures.” Fatigue or weakness may occur because of anemia (low red blood cell count). People may also have frequent infections due to weaker immune function, or kidney problems caused by abnormal proteins made by the cancer cells.
Multiple myeloma can also lead to high calcium levels in the blood, which may cause nausea, confusion, or constipation. High calcium can be dangerous and even life-threatening. If these symptoms appear, it is important to seek medical attention right away.
ExaminationThe doctor will do a thorough physical exam, checking for areas of bone tenderness, especially in the spine, pelvis, or long bones (arms and legs). They may also look for signs of anemia, such as pale skin. A neurological exam is important too, to make sure the nerves are working properly.
Tests
Testing for multiple myeloma usually includes blood and urine tests. These check for anemia (low red blood cells), kidney function, calcium levels, and abnormal proteins made by the cancer cells. Special tests called serum protein electrophoresis (SPEP) and urine protein electrophoresis (UPEP) are commonly used to find these abnormal proteins.
Imaging tests such as X-rays or MRI (magnetic resonance imaging) can show bone damage, and a PET/CT scan helps identify if the disease has spread in the body. The most important step is a biopsy, where a small piece of tissue is removed and examined under a microscope to confirm the diagnosis.
Images
Figure 1: X-ray of thigh bone demonstrating “punched-out” loss of bone on the left; right image demonstrating prophylactic fixation with an intramedullary rod.

Figure 2: Microscopic view of biopsy tissue demonstrating abnormal plasma cells.
Prognosis
The outlook for multiple myeloma can vary depending on the stage of the disease (how advanced it is) and the genetic features of the cancer cells. On average, the five-year survival rate is about 60%. New treatments have improved outcomes, especially for patients younger than 60.
Myeloma is not considered curable, but treatment can help control it for many years. Therapy often includes steroids, chemotherapy, medicines to strengthen the bones, and radiation to affected bones. Surgery may be needed to repair weakened or broken bones—most often in the long bones or spine—or to relieve pressure on the spinal cord in emergencies.
It is important to see an Orthopedic Oncologist (a bone cancer specialist) if the bones are affected, so they can help guide treatment and protect bone strength.
More Information
Multiple Myeloma Research Foundation - https://themmrf.org/multiple-myeloma/
American Cancer Society - https://www.cancer.org/cancer/types/multiple-myeloma.html
European Society for Medical Oncology - https://www.esmo.org/for-patients/patient-guides/multiple-myeloma
Multiple Myeloma, Orthoinfo- https://orthoinfo.aaos.org/en/diseases--conditions/multiple-myelomaplasmacytoma/#:~:text=While%20there%20is%20no%20cure,keep%20them%20on%20maintenance%20therapy.
This is not intended as a substitute for professional medical advice and does not provide advice on treatments or conditions for individual patients. All health and treatment decisions must be made in consultation with your physician(s), utilizing your specific medical information. Inclusion in this is not a recommendation of any product, treatment, physician or hospital.


